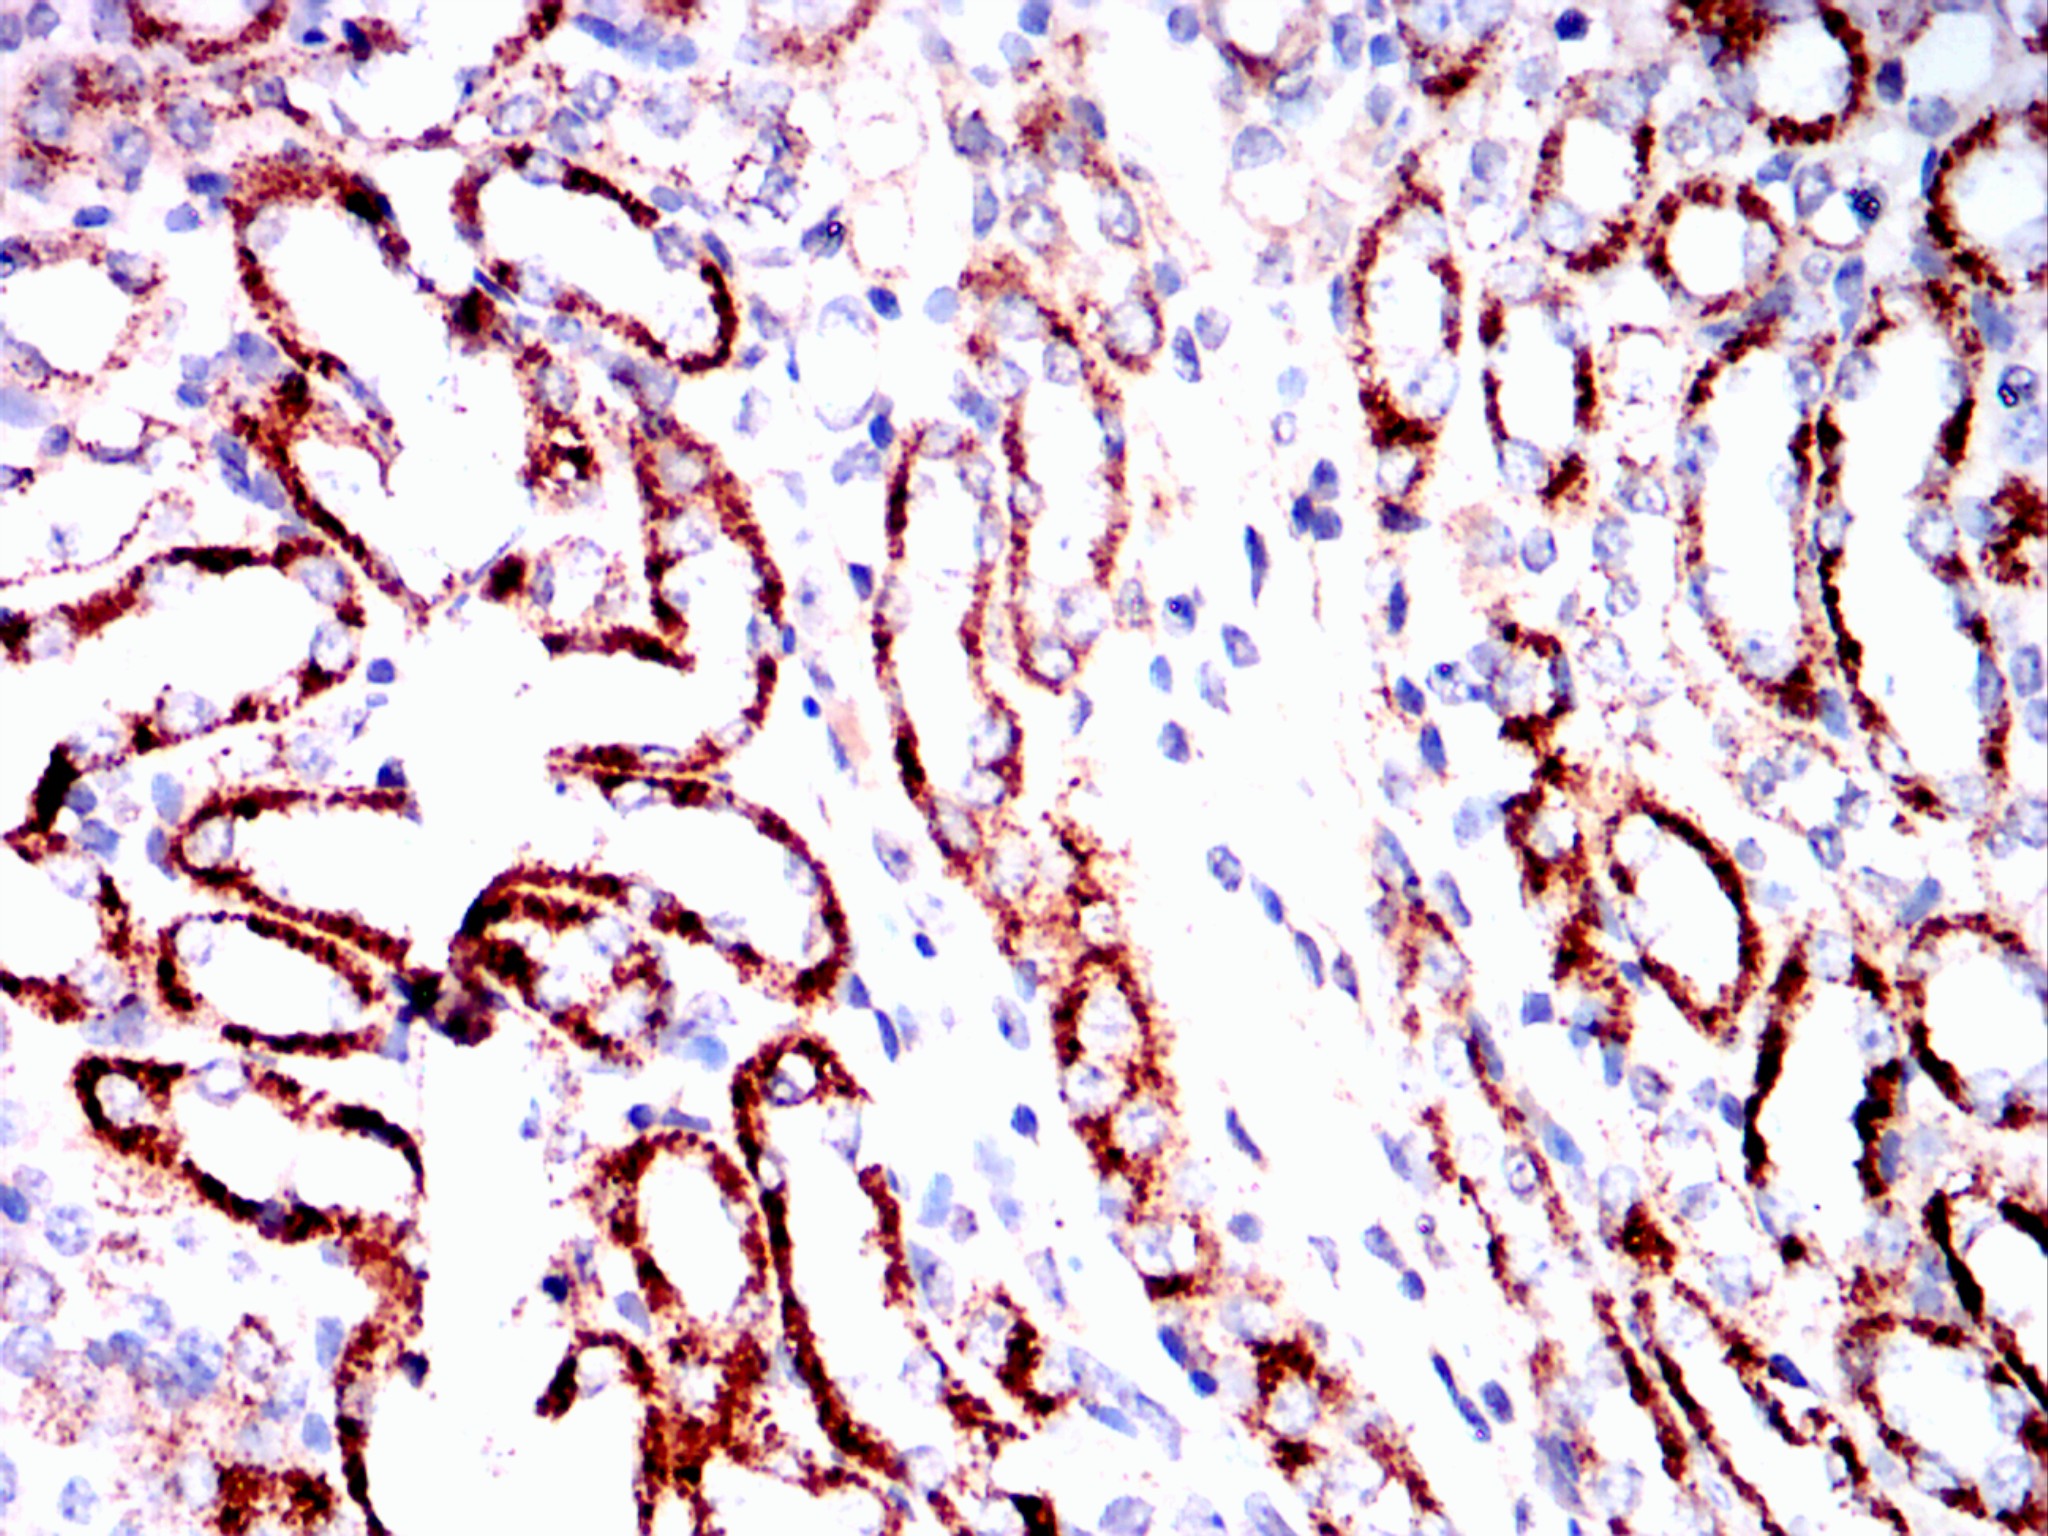

Mouse Monoclonal Antibody to IKBKE
货号:
20174
别名:
IKBKE
应用:
FCM,IHC
反应种属:
Human
抗体类型:
Primary antibody
Swissprot:
Q14164
规格:
目录价
在线咨询
Description |
|---|
Serine/threonine kinase that plays an essential role in regulating inflammatory responses to viral infection, through the activation of the type I IFN, NF-kappa-B and STAT signaling. Also involved in TNFA and inflammatory cytokines, like Interleukin-1, signaling. Following activation of viral RNA sensors, such as RIG-I-like receptors, associates with DDX3X and phosphorylates interferon regulatory factors (IRFs), IRF3 and IRF7, as well as DDX3X. This activity allows subsequent homodimerization and nuclear translocation of the IRF3 leading to transcriptional activation of pro-inflammatory and antiviral genes including IFNB. In order to establish such an antiviral state, IKBKE forms several different complexes whose composition depends on the type of cell and cellular stimuli. Thus, several scaffolding molecules including IPS1/MAVS, TANK, AZI2/NAP1 or TBKBP1/SINTBAD can be recruited to the IKBKE-containing-complexes. Activated by polyubiquitination in response to TNFA and interleukin-1, regulates the NF-kappa-B |
References |
|---|
| 1. Cell. 2007 Jun 15;129(6):1065-79. 2. Mol Syst Biol. 2007;3:89. Epub 2007 Mar 13. 3. Arthritis Rheum. 2007 Mar;56(3):743-52. |
Specification |
|
|---|---|
| Aliases | IKBKE |
| Entrez GeneID | 9641 |
| Swissprot | Q14164 |
| clone | 6B4B5 |
| Host/Isotype | Mouse IgG1 |
| Antibody Type | Primary antibody |
| Storage | Store at 4°C short term. Aliquot and store at -20°C long term. Avoid freeze/thaw cycles. |
| Species Reactivity | Human |
| Immunogen | Purified recombinant fragment of IKBKE (aa1-257) expressed in E. Coli. |
| Formulation | Ascitic fluid containing 0.03% sodium azide. |
Application |
|
|---|---|
| IHC | 1/200 - 1/1000 |
| FCM | 1/200 - 1/400 |
| ELISA | 1/10000 |
Product Image
-
Flow cytometric analysis of hela cells using IKBKE mouse mAb (green) and negative control (red).

-
Flow cytometric analysis of NH3T3 cells using IKBKE mouse mAb (green) and negative control (red).

-
Immunohistochemical analysis of paraffin-embedded rat kidney tissues using IKBKE mouse mAb with DAB staining.

-
Immunohistochemical analysis of paraffin-embedded human lung cancer tissues using IKBKE mouse mAb with DAB staining.

-
Immunohistochemical analysis of paraffin-embedded human colon cancer tissues using IKBKE mouse mAb with DAB staining.

-
Immunohistochemical analysis of paraffin-embedded rabbit liver tissues using IKBKE mouse mAb with DAB staining.

-
Immunohistochemical analysis of paraffin-embedded rabbit kidney tissues using IKBKE mouse mAb with DAB staining.

-
Immunohistochemical analysis of paraffin-embedded rabbit lmouse tissues using IKBKE mouse mAb with DAB staining.

-
Immunohistochemical analysis of paraffin-embedded mouse kidney tissues using IKBKE mouse mAb with DAB staining.

鄂公网安备42018502007531号

